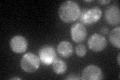
YFR044C
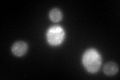
YFR044C
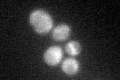
YFR044C
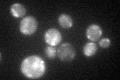
YFR044C

View description
Cys-Gly metallo-di-peptidase; forms a complex with Dug2p and Dug3p to degrade glutathione (GSH) and other peptides containing a gamma-glu-X bond in an alternative pathway to GSH degradation by gamma-glutamyl transpeptidase (Ecm38p)
Localization:
Intensity:
Fold change:
Significance:
-
C’ GFP library in SD
cytosol:mitochondria52.43 -
N' NOP1pr-GFP in SD

cytosol262.196 -
N' TEF2pr-mCherry in SD

missing0 -
N' NATIVEpr-GFP in SD

missing0 -
N' TEF2pr-VC and Cyto-VN in SD

#N/A0 -
C’ GFP library in SD+DTT
cytosol.mitochondria100.991.92Yes -
C’ GFP library in SD+H2O2
cytosol.mitochondria61.051.16No -
C’ GFP library in Starvation Media
cytosol,mitochondria74.091.41Yes -
C’ GFP library on the background of Pup2-DaMP

cytosol:mitochondria -
C’ GFP library on the background of CCT mutant

cytosol:mitochondria61.05651.16447No
